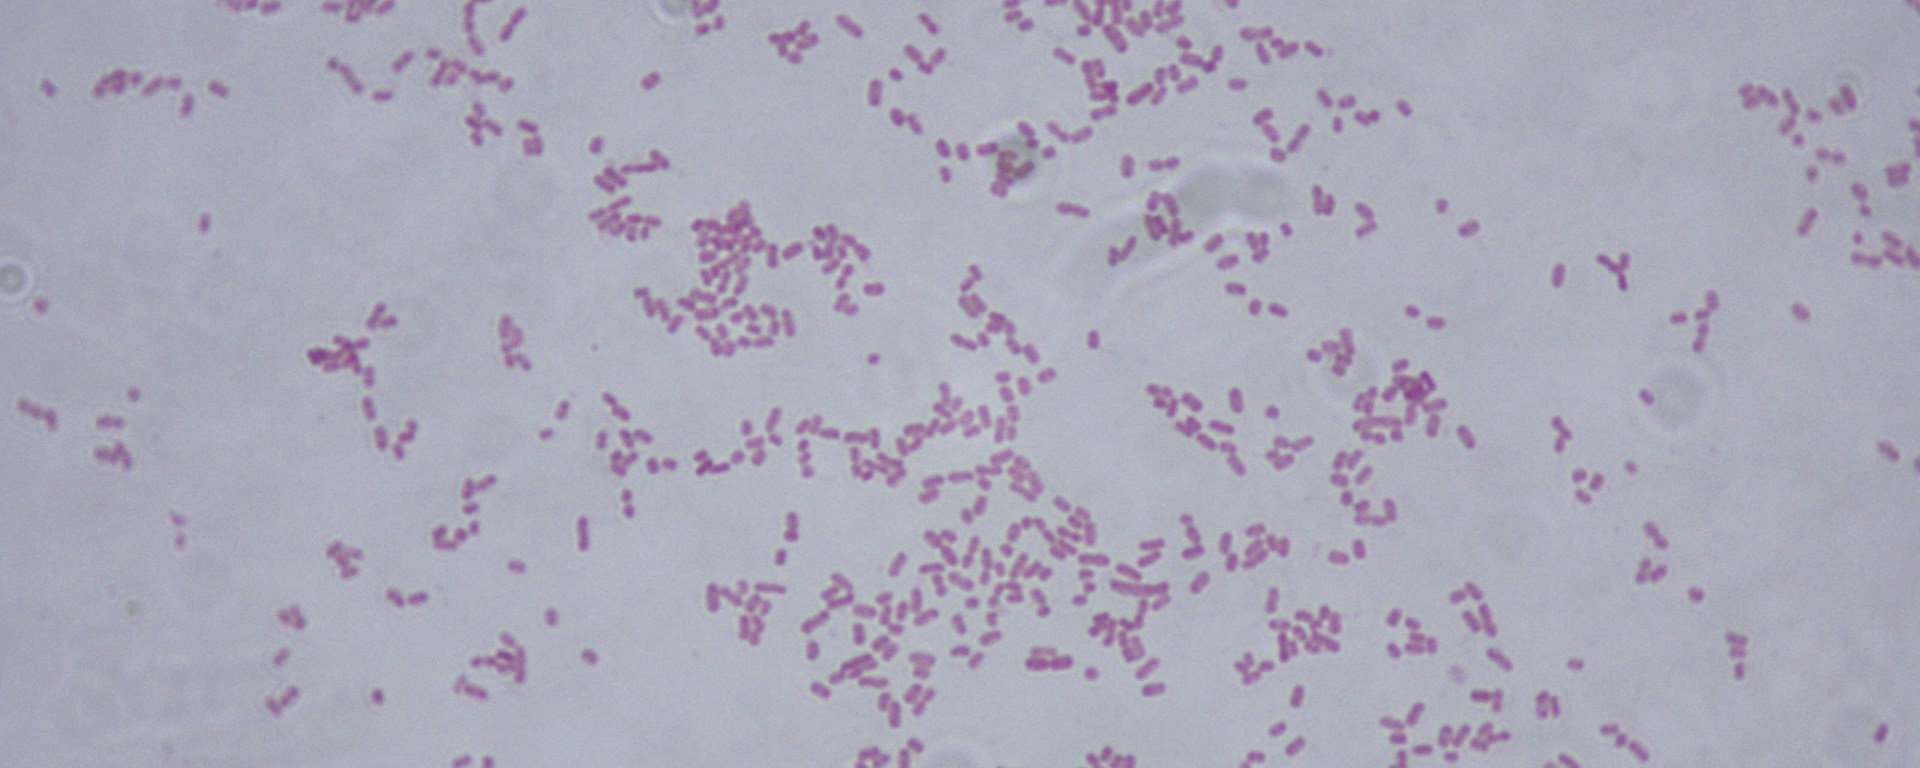

La última en octubre se detectaron dos recién nacidos con sepsis por la bacteria de klebsiella.
Fueron aislados siete menores por contagio de la bacteria.
El subdirector de epidemiología de los Servicios de Salud Francisco Cervantes Durán informó que la última semana del mes de octubre se detectó a dos recién nacidos con sepsis por klebsiella en el Hospital General de Valles, por lo que se procedió a realizar muestras a cinco infantes más, aislando a un total de siete menores en el área de neonatos.
De acuerdo a las muestras tomadas, los siete recién nacidos resultaron positivos a la bacteria de klebsiella, dos de ellos evolucionaron favorablemente y fueron dados de alta, dos continúan hospitalizados, uno fue traslado a la capital del Estado en dónde fue ingresado al Hospital General de Zona No. 1 del Instituto Mexicano del Seguro Social (IMSS), y dos fallecieron.
El pequeño referido al IMSS fue por derechohabiencia y presenta además una malformación congénita cardiaca y se encuentra recibiendo atención médica; en cuanto a las dos defunciones, el médico señaló que obedecieron a Neumonía por Klebsiella Pneumoniae y prematurez extrema y síndrome de distress respiratorio.
Las bacterias del tipo klebsiella son unos microorganismos que se encuentran en el intestino de los seres humanos, si llega a otras partes del organismo puede causar infecciones que normalmente provocan neumonía, sepsis, infecciones en heridas y en el tracto urinario; cuando no se controlan, pueden causar la muerte. Las personas bajas de defensas, como bebés prematuros, pacientes de cuidados intensivos, son quienes más riesgo tienen de desarrollar una infección por esta bacteria.
Por su parte, la directora del Hospital General de Valles, Mónica González Mojica explicó que cuando un bebé nace antes de tiempo, tiene problemas de salud o nace en un parto difícil, va a la unidad de cuidados intensivos neonatales (UCIN), y los neonatos recibidos en el área de UCIN del Hospital son pacientes con prematurez extrema por complicaciones del embarazo.
La UCIN, dijo, cuenta con un reglamento con medidas de protección personal estrictas por tratarse de una área que maneja pacientes en estado de Salud Grave o delicado dentro de las medidas de protección establecidas se encuentra lavado de manos antes de ingresar a dicha área, bata hospitalaria, guantes, cubrebocas y en ocasiones mascarilla y gorro quirúrgico, tanto para trabajadores de la salud como para visitantes. La permanencia de familiares que ingresa a esta área está limitada a las condiciones del neonato en las horas establecidas para las visitas y durante poco tiempo.
El personal médico adscrito a esta área es el único responsable de proporcionar el estado de salud de los pacientes a los familiares.
Cabe mencionar que el área de UCIN, Módulo mater y Quirófanos cuentan con aire acondicionado funcional, y estás áreas se encuentran separadas y aisladas del área de hospitalización, y el personal asignado a UCIN es independiente al personal que labora en otras áreas.